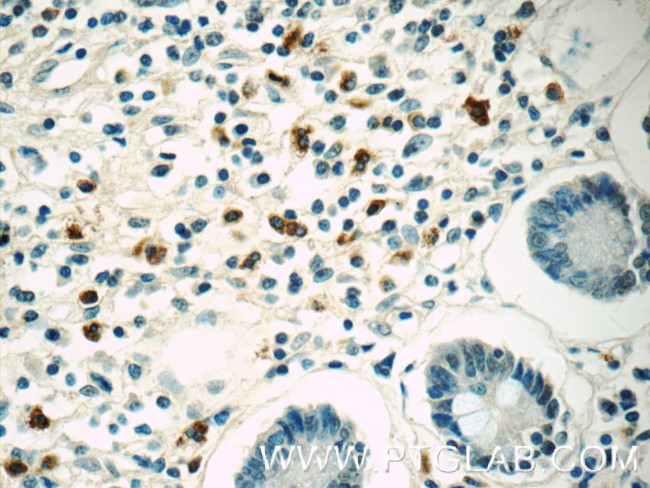
IL-28A Antibody in Immunohistochemistry (Paraffin) (IHC (P))

Search
Proteintech
IL-28A Monoclonal Antibody (3B4A1)
{{$productOrderCtrl.translations['antibody.pdp.commerceCard.promotion.promotions']}}
{{$productOrderCtrl.translations['antibody.pdp.commerceCard.promotion.viewpromo']}}
{{$productOrderCtrl.translations['antibody.pdp.commerceCard.promotion.promocode']}}: {{promo.promoCode}} {{promo.promoTitle}} {{promo.promoDescription}}. {{$productOrderCtrl.translations['antibody.pdp.commerceCard.promotion.learnmore']}}
产品信息
60270-1-IG
种属反应
宿主/亚型
分类
类型
克隆号
抗原
偶联物
形式
浓度
规格
纯化类型
保存液
内含物
保存条件
运输条件
产品详细信息
Immunogen sequence: TVTGAVPVA RLHGALPDAR GCHIAQFKSL SPQELQAFKR AKDALEESLL LKDCRCHSRL FPRTWDLRQL QV (21-91 aa encoded by BC113583)
靶标信息
IL-28A belongs to the IFN lambda family, a novel family of cytokines within the IL-10 superfamily. The three members of this family are IL-29 (IFN lambda 1), IL-28A (IFN lambda 2), and IL-28B (IFN lambda 3), and are also known as the type III Interferons.The IFN lambdas signal through a heterodimeric receptor of which one subunit, IL-10R2, is shared with other members of the superfamily. The second subunit, IFN lambda R1 or IL-28R alpha, is unique to the IFN lambdas. Signaling occurs through the Jak/STAT pathway in a similar manner as the type I IFN (IFN alpha/beta) and activates many of the same genes despite low sequence homology between the cytokines and receptors in the two families. Both IFN families display antiviral activity through the induction of antiviral protein production in target cells and the upregulation of MHC class I expression. These proteins also exhibit antiproliferative and antitumor effects, making them a possible alternative to IFN alpha cancer therapies. Unlike the type I IFN, which are able to stimulate most cells, response to IFN lambda stimulation appears to be limited to dendritic and some tumor cells due to the limited expression of IFN lambda R1. Another notable difference is the ability of the IFN lambda stimulation to drive dendritic cells towards the production of CD4+CD25+FoxP3+ regulatory T cells, suggesting a possible immunoregulatory role
仅用于科研。不用于诊断过程。未经明确授权不得转售。
篇参考文献 (0)
生物信息学
蛋白别名: cytokine; Cytokine Zcyto20; IFN-lambda-2; IFN-lambda2; cytokine; IL-28A; ILN; Interferon lambda-2; Interleukin; interleukin 28A (interferon, lambda 2); Interleukin-28A
基因别名: IFNL2; IFNL2a; IFNL3a; IL-28A; IL28A; ZCYTO20
UniProt ID: (Human) Q8IZJ0
Entrez Gene ID: (Human) 282616